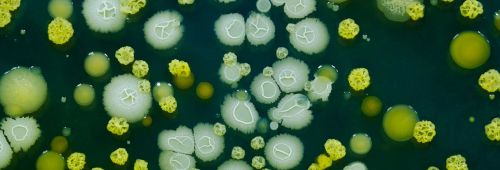
Archisio - Giesse Disinfestazioni - Progetto Disinfezioni

Giesse Disinfestazioni
Derattizzazioni - Sassari (SS)

Monitoraggio e intervento per roditori in sardegna
La giesse disinfestazioni interviene per disinfestare gli ambienti da roditori portatori di malattie infettive e da organismi potenzialmente patogeni. Questi servizi sono dedicati al debellamento dei topi, fastidiose presenze che portano numerosi aspetti negativi di varia natura negli ambienti umani.
Al giorno d’oggi vi sono malattie riconosciute come associate ai roditori che assumono importanza a livello mondiale, come la leptospirosi e la salmonellosi. Ma non solo le malattie, i roditori sono protagonisti anche di danni materiali di distruzione o contaminazione, che può avvenire mediante peli, ma anche feci o urine, che possono andare a contatto con derrate alimentari di ogni genere.
Ma i danneggiamenti possono anche riguardare strutture di vario genere, attraverso l’utilizzo degli incisivi dei roditori: pensate infatti ai danni che possono arrecare nel caso di cavi elettrici, o di altro genere, che possono bloccare la vostra abitazione o attività produttiva.
Giesse per combattere questi fenomeni effettua interventi di derattizzazione utilizzando esclusivamente esche alimentari avvelenate. Tali esche appartengono alla categoria dei rodenticidi cronici anticoagulanti a dose singola. Essi provocano un’alterazione della coagulazione del sangue, deteriorano i capillari, causando la morte per piccole emorragie interne. Tutti questi prodotti sono ben accetti dai roditori. Questa tipologia di esca ha anche un’azione insetticida e fungicida che previene il deterioramento e l’infestazione delle esche stesse.
Disinfestazioni - Sassari (SS)

La giesse disinfestazioni interviene per disinfestare gli ambienti da insetti portatori di malattie infettive e da organismi potenzialmente patogeni. Questi servizi sono dedicati al debellamento di: zanzare, pappataci, mosche, cimici, pulci, scarafaggi e blatte. Le zanzare possono dare origine ad una vastità di problemi sanitari. Le problematiche per questi insetti si rinnovano continuamente a causa dell’adattamento di alcune specie ad ambienti le cui caratteristiche originarie sono state fortemente alterate dall’azione dell’uomo (flora, vegetazione, fauna, ecc), e nel contempo alla graduale ricolonizzazione delle zone boscate dalla malaria.
Il pappatacio spesso viene chiamato col termine di zanzara killer, anche se l’unica cosa che ha in comune con la zanzara è la sua necessità di doversi cibare di sangue per dare da mangiare alle proprie uova, e che è l’esemplare femminile a pungere. Si tratta però di un piccolo insetto, il cui corpo non supera i 3 mm con un colore che va da quasi bianco al quasi nero. è peloso e mentre punge dispone le ali ad angolo sopra l’addome.
Abbiamo poi le mosche ed i mosconi che li troviamo principalmente in ambienti a forte alterazione umana (centri urbani). Alcune specie hanno infatti bisogno dell’uomo per proliferare, mentre altre invece possono anche svilupparsi in ambienti più rurali. La durata della vita delle forme adulte è, mediamente, di 30/35 giorni ed è legata alla temperatura e al tipo di dieta. La mosca domestica si nutre di qualsiasi sostanza organica liquida o semi – liquida oltre a materiale organico solido che ha pretrattato con la sua saliva o vomito. La mosca deposita feci in maniera praticamente costante e questo è uno dei fattori che rende questo insetto un vettore di patogeni nefasto e molto pericoloso.
Le pulci sono insetti ematofagi obbligatori che si diffondono in ambiente urbano grazie alla presenza di animali da compagnia nelle nostre abitazioni, alla difficoltà di trovare molecole insetticide efficaci e alla scarsa conoscenza del ciclo biologico di questi artropodi. Le nostre abitazioni sono l’habitat ideale per lo sviluppo e il mantenimento delle pulci che infestano principalmente cani, gatti ma anche l’uomo. Sono molto temuti in medicina veterinaria a causa delle lesioni cutanee causate dalle loro punture sugli animali e sull’uomo.
Abbiamo poi le zecche, di cui molte delle patologie trasmesse da questi inetti sono definite “emergenti” per l’aumento delle segnalazioni negli animali e nell’uomo. Le probabilità per l’uomo di contrarre malattie trasmesse da zecche sono aumentate negli ultimi anni per via degli incontri più ravvicinati con la natura, con l’agriturismo e con l’incremento del numero dei cani nel verde pubblico che forniscono nuove opportunità di incontro uomo – zecca. Le malattie infettive trasmesse da zecche sono molte e possono essere patologie batteriche e virali.
Il controllo delle blatte rappresenta un settore molto importante. Non esiste ambiente in cui le blatte non riescano ad insediarsi creando disagi sul piano igienico–sanitario. Gli interventi di controllo sono di due tipi: disinfestazioni classiche, con l’impiego di disinfestanti ed attrezzature tradizionali e disinfestazioni moderne, con l’introduzione del monitoraggio ambientale e dei formulati gel. Questi interventi sono atti alla eliminazione delle principali due specie di blatte che prolificano: la blattella germanica (fuochista) e la blatta orientalis (scarafaggio). Ma si sta diffondendo anche la periplaneta americana (blatta americana). Le blatte sono insetti onnivori con abitudini notturne. Le uova delle blatte sono contenute nelle ooteche da cui usciranno giovani blatte. Gli habitat ideali sono rappresentati dai luoghi caldi ed umidi. All’interno delle industrie alimentari le zone più infestate sono rappresentate da crepe e da fessure nelle pareti e nei pavimenti, sotto i pavimenti, negli impianti elettrici, nei canali di scolo, ecc. Nelle abitazioni private i punti di maggior concentrazione di blatte sono rappresentati dalle cucine.
Disinfezioni - Sassari (SS)
Al servizio di enti pubblici e aziende della sardegna
La giesse disinfestazioni mette a disposizione della clientela servizi relativi alle disinfezioni ambientali, che vengono effettuati sia per privati ma anche al servizio di enti pubblici e aziende. Spesso ci dimentichiamo che l’aria stessa che respiriamo è una miscela di gas e microbi.
Tutti i giorni inevitabilmente ci confrontiamo con essi. La maggioranza dei microbi ci sono del tutto indifferenti. Alcuni microbi, addirittura, ci permettono di assimilare alcuni cibi e svolgono una funzione fondamentale nella trasformazione di alcuni alimenti. Si può convivere con i microbi, basta promuovere lo sviluppo di quelli “buoni” e sfavorire ed eliminare quelli “cattivi”.
Un uso mirato di disinfettanti e antisettici deve essere la base di una sanificazione ambientale. Per quanto riguarda l’uso mirato di disinfettanti occorre valutare 2 fattori: lo spettro d’azione e il tempo d’azione. In merito all’attrezzatura specifica ci si avvale di strumenti all’avanguardia con i tempi per effettuare disinfezione ambientali impeccabili, in particolar modo nebulizzatori.
L’obiettivo di un’azione di disinfezione ambientale (in ambiente civile come un ufficio) non è ottenere un luogo sterile ma un livello igienico coerente con l’ambiente in cui si opera.
Monitoraggio a norma haccp in sardegna - Sassari (SS)

La giesse disinfestazioni offre anche servizi complessi nel campo della disinfezione, come il monitoraggio a norma haccp. Un lavoro delicato, che parte dalla corretta ed efficace predisposizione di un piano di monitoraggio e controllo degli insetti e dei roditori nelle realtà operanti nel settore alimentare (cucine degli hotel, bar, ristoranti, industrie alimentari, ecc.). Il servizio che offriamo si compone delle seguenti fasi:
Ispezioni;
Allestimento di sistemi di monitoraggio;
Presentazione di consigli atti a prevenire l’insorgere di infestazioni;
Applicazione di insetticidi e derattizzanti;
Verifica dei risultati;
Stesura di relazioni puntuali e riepilogative.
Per poter gestire il servizio, la ditta valuterà, a seguito del monitoraggio, se la causa dell’infestazione è interna all’azienda alimentare, se l’infestazione è occasionale e si è generata per contaminazione dall’ambiente esterno ed, infine, se le misure adottate dall’azienda alimentare sono in grado di impedire efficacemente l’entrata agli infestanti.
Uno degli obblighi derivanti dal piano di autocontrollo haccp è quello del monitoraggio infestanti. è un obbligo di legge che se non osservato può portare a sanzioni da parte dei vari organi di controllo come asl, nas, ecc. Le cose fondamentali da fare sono 2:
Il monitoraggio di blatte e scarafaggi
Il monitoraggio di ratti
Si tratta di piazzare all'interno dei locali in punti strategici dei dispositivi di monitoraggio. Nel caso si rilevi la presenza di infestanti si deve provvedere ad un piano di disinfestazione o derattizzazione eseguito da ditta specializzata. è obbligatorio solo il monitoraggio. Ovviamente strutture che operano all'aperto o in zone "a rischio" quindi vicino a giardini, fiumi o in zone di campagna sono potenzialmente più esposti a questo problema pertanto devono porre grande attenzione nell'affrontarlo. Capita però che una volta "messi in regola" con la normativa haccp per quanto riguarda il monitoraggio di infestanti la cosa venga più o meno dimenticata.
Trappole ad accessori - Sassari (SS)

Lampade uva e trappole per roditori in sardegna
La giesse disinfestazioni mette in campo le migliori e più moderne soluzioni per quanto attiene il compimento dei propri servizi di sanificazione ambientale. Si commercializzano e posano in opera lampade uva e trappole per roditori, erogatori e accessori per il monitoraggio di insetti e roditori. In particolare:
Contenitori in policarbonato di colore nero per il monitoraggio e la cattura di blatte ed altri insetti striscianti
Trappole adesive in plastica ideali per il monitoraggio di blatte ed insetti striscianti in generale, con attrattivo alimentare
Lampade uv (trappole luminose a piastra collante): sono un valido strumento per la cattura e il monitoraggio degli insetti volanti in ambito alimentare
Tubi uv (neon per lampade uv)
Tavolette collanti, accessori e ricambi per lampade uv
Erogatori di esca rodenticida
Trappole e collanti per la cattura dei roditori
Come detto questi prodotti potrete acquistarli da soli oppure in combinazione con i servizi relativi che permettono di non avere nessuna incombenza e preoccupazione grazie al lavoro messo in campo dal nostro personale esperto che verrà incontro alle vostre necessità andando ad eliminare gli ospiti indesiderati dalla vostra abitazione, azienda e ente pubblico. Non esitate quindi a rivolgervi a giesse per ogni tipologia di richiesta o necessità legate ad interventi di sanificazione ambientale quali disinfezioni, disinfestazioni e derattizzazioni.
Invia una richiesta di lavoro a Giesse Disinfestazioni
Trova i migliori Disinfestazioni Derattizzazioni a
Roma| Milano| Napoli| Torino| Palermo| Genova| Bologna| Firenze| Bari| Catania| Venezia| Verona| Messina| Padova| Trieste| Taranto| Brescia| Parma| Prato| Modena| Perugia| Ravenna| Livorno| Cagliari
Vedi tutti
Trova altri professionisti a Sassari
Architetti| Imprese Edili| Imprese di Impianti Elettrici ed Elettricisti| Imprese di Traslochi| Imprese di Ponteggi| Imprese di Costruzioni Ecologiche| Ingegneri Edili| Imprese di Tende da Interni| Imprese di Bonifica Eternit| Rivenditori di Arredo Giardino ed Esterni| Rivenditori di Camini e Stufe| Rivenditori di Cucine| Geometri| Rivenditori di Illuminazione| Rivenditori di Arredamento| Rivenditori di Pavimenti e Rivestimenti| Fotografi di Interni| Rivenditori di Piscine| Designer di Interni| Artisti| Imprese di Tinteggiature| Parquettisti| Marmisti| Imprese di Impianti di Climatizzazione
Vedi tutti
Disinfestazioni Derattizzazioni vicino a te

